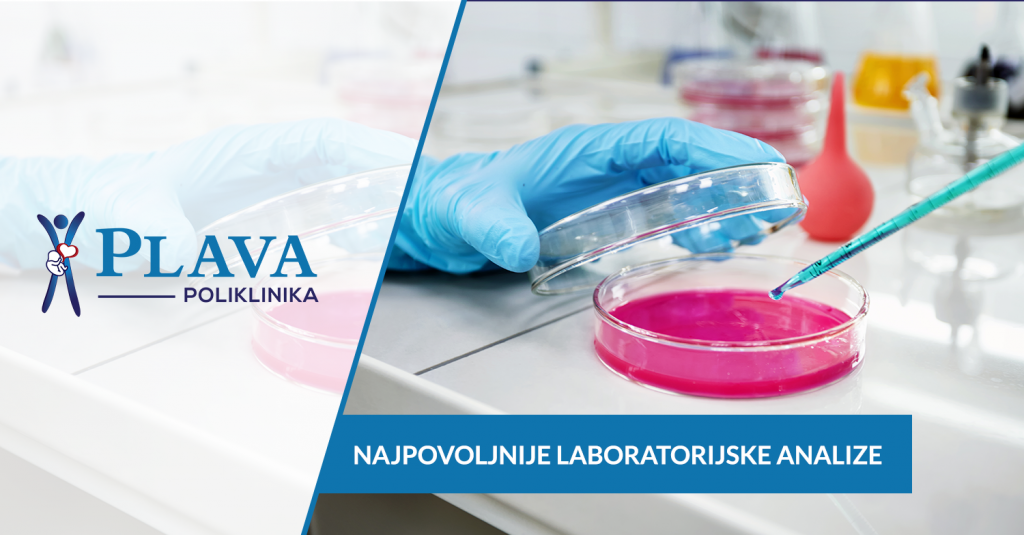

PZU Plava Poliklinika koja je nedavno proširila djelokrug rada otvaranjem multidiciplinarne specijalne bolnice u centru Tuzle te Plave Lab i poliklinike na Slatini, sada je pacijentima omogućila i najpovoljnije cijene laboratorijskih analiza na svim lokacijama.
Razloge zbog kojih su se odlučili na ovaj korak, značajan za građane Tuzlanskog kantona, otkrio nam je član Uprave – dr. Ahmed Hujdurović.
“Zbog činjenice da laboratorijske analize imaju ključnu ulogu u postavljanju tačne dijagnoze i da je više od tri četvrtine svih dijagnoza zasnovano na laboratorijskim nalazima, odlučili smo da našim pacijentima omogućimo dosadašnji kvalitet laboratorijskih analiza po najpristupačnijim cijenama – na tri lokacije. Time želimo da se odužimo pacijentima za povjerenje koje nam ukazuju preko dvadeset godina a ujedno i da ih potaknemo na češće preventivne laboratorijske pretrage, jer je samo prevencijom moguće spriječiti vodeće bolesti današnjice.” – ističe dr. Hujdurović
Prema njegovim riječima, pacijentima je u laboratoriji Plave Poliklinike dostupno preko 2500 laboratorijskih pretraga sa najvišim stepenom pouzdanosti.
” Zahvaljujući stručnom osoblju, kvalitetnoj opremi i korištenju reagenasa svjetski priznatih proizvođača vrhunskog kvaliteta, uz poštovanje principa dobre laboratorijske prakse, pacijenti se mogu osloniti na rezultate naših laboratorijskih analiza, koji će ostati pouzdani, tačni i brzi. Želim istaći da je dodatna prednost primjena dosadašnjeg kocepta sveobuhvatne usluge koji je posebno značajan za laboratorijske analize jer je pacijentima omogućeno da na istom mjestu dobiju i očitavanje nalaza od strane stručnog lica. “- dodao je dr. Hujdurović.
Kompletan cjenovnik sa jedinstvenim cijenama koje važe na svim lokacijama Plave Poliklinike možete preuzeti na ovom linku.